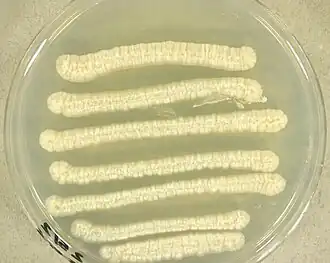

Trichosporon
| Trichosporon | ||||||||||||
|---|---|---|---|---|---|---|---|---|---|---|---|---|
Trichosporon asteroides auf Kartoffel-Dextrose-Agar | ||||||||||||
| Systematik | ||||||||||||
| ||||||||||||
| Wissenschaftlicher Name | ||||||||||||
| Trichosporon | ||||||||||||
| Behrend, 1890 |
Trichosporon ist eine Gattung Hefen. Die Typspezies ist Trichosporon ovoides. Phylogenetisch ähnliche Gattungen sind Bullera, Cryptococcus und Cryptotrichosporon.[1]
Beschreibung
Die Kolonien dieser Gattung sind cremefarben. Echtes Mycel ist vorhanden und Pseudomycel fehlt in der Gattung. Arthrokonidien sind in der Regel reichlich vorhanden und seitlich können auch keulenförmige Konidien vorhanden sein. Septen der Hyphen sind meist mit Doliporen versehen.[2]
Taxonomie
Die erste Spezies war Trichosporon ovoides, welche die seltene Pilzinfektion des Haarschafts namens Weiße Piedra verursacht.[3] Die Gattung teilte sich lange in 4 bzw. 5 Kladen (Gracile, Cutaneum, Porosum, Ovoides) auf.[4] Liu beschränkte die Gattung allerdings auf die Klade Trichosporon inclusive ovoides und stellt die übrigen Kladen in eigene Gattungen. Daher beinhaltet die Gattung nun noch folgende 12 Arten:[5]
- Trichosporon aquatile
- Trichosporon asahii
- Trichosporon asteroides
- Trichosporon caseorum
- Trichosporon coremiiforme
- Trichosporon dohaense
- Trichosporon faecale
- Trichosporon inkin
- Trichosporon insectorum
- Trichosporon japonicum
- Trichosporon lactis
- Trichosporon ovoides
Habitat
Trichosporon ist mit dem Erdreich und Gewässern assoziiert, findet sich jedoch auch häufig in Lebensmitteln wieder.[4]
Pathogenität
Die sechs Spezies Trichosporon asahii, Trichosporon asteroides, Trichosporon cutaneum (jetzt Cutaneotrichosporon cutaneum[5]), Trichosporon inkin, Trichosporon mucoides (jetzt Cutaneotrichosporon mucoides[5]), Trichosporon ovoides sind medizinisch relevant. Patienten mit Leukämie oder Lymphom können an der Trichosporonose versterben.[6]
Einzelnachweise
- ↑ Takashi Sugita: The Yeasts (Fifth Edition). Elsevier, London 2011, ISBN 978-0-444-52149-1, Chapter 161 - Trichosporon Behrend (1890), S. 2015–2061, doi:10.1016/b978-0-444-52149-1.00161-0.
- ↑ E. Guého, M. Th. Smith, G. S. de Hoog: The Yeasts (Fourth Edition). Elsevier, Amsterdam 1998, ISBN 978-0-444-81312-1, 110 - Trichosporon Behrend, S. 854–872, doi:10.1016/B978-044481312-1/50115-5.
- ↑ E. Guého, G. S. de Hoog, M. T. Smith: Neotypification of the genus Trichosporon. In: Antonie Van Leeuwenhoek. Band 61, Nr. 4, 1992, ISSN 0003-6072, S. 285–288, doi:10.1007/BF00713937, PMID 1497333.
- ↑ a b Wouter J. Middelhoven, Gloria Scorzetti, Jack W.YR 2004 Fell: Systematics of the anamorphic basidiomycetous yeast genus Trichosporon Behrend with the description of five novel species: Trichosporon vadense, T. smithiae, T. dehoogii, T. scarabaeorum and T. gamsii. In: International Journal of Systematic and Evolutionary Microbiology. Band 54, Nr. 3, ISSN 1466-5034, S. 975–986, doi:10.1099/ijs.0.02859-0.
- ↑ a b c X.-Z. Liu, Q.-M. Wang, M. Göker, M. Groenewald, A.V. Kachalkin: Towards an integrated phylogenetic classification of the Tremellomycetes. In: Studies in Mycology. Band 81, 2015, S. 85–147, doi:10.1016/j.simyco.2015.12.001, PMID 26955199.
- ↑ Takashi Sugita, Akemi Nishikawa, Reiko Ikeda, Takako Shinoda: Identification of Medically RelevantTrichosporon Species Based on Sequences of Internal Transcribed Spacer Regions and Construction of a Database forTrichosporon Identification. In: Journal of Clinical Microbiology. 1999, doi:10.1128/JCM.37.6.1985-1993.1999.